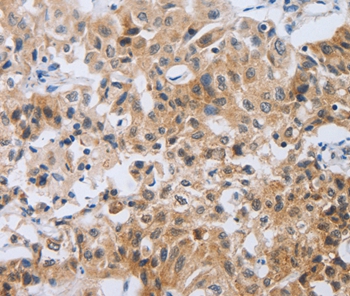

NEB / Nebulin Antibody (clone Neb-20, Magnetic beads)
LS-C171212
ApplicationsImmunoPrecipitation
Product group Antibodies
TargetNEB
Overview
- SupplierLifeSpan BioSciences
- Product NameNEB / Nebulin Antibody (clone Neb-20, Magnetic beads)
- Delivery Days Customer23
- ApplicationsImmunoPrecipitation
- Applications SupplierIP
- CertificationResearch Use Only
- ClonalityMonoclonal
- Clone IDNeb-20
- ConjugateBioMagnetic Particle
- Estimated Purity...
- Gene ID4703
- Target nameNEB
- Target descriptionnebulin
- Target synonymsAMC6; NEB177D; nebulin; NEM2; nemaline myopathy type 2
- HostMouse
- IsotypeIgG1
- Storage Instruction2°C to 8°C
- UNSPSC12352203